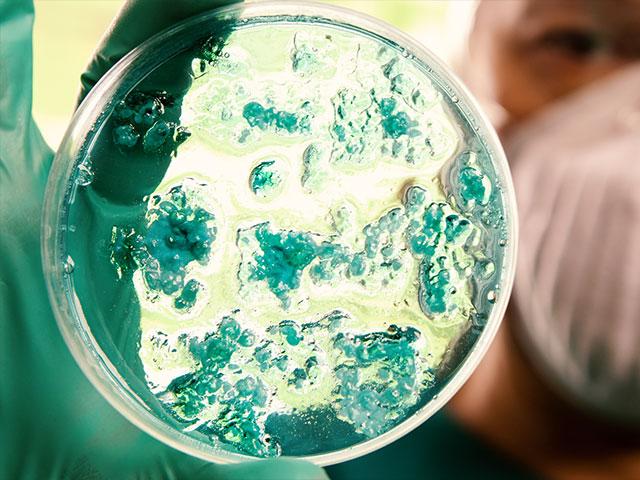

There's been a noticeable drop in terror attacks over the past several months. No one would deny it's easy to get used to the decrease in notices of attempted stabbings, bombings, drive-by shootings and the like.
The Supreme Court has temporarily stayed a lower court ruling that would have forced a Virginia school district to let a transgender male student use the bathroom of his choice.
A new law Egypt is considering would streamline the construction of churches even as violence against Christians in the country continues to rise.
A South Carolina resident is clinging to life after being infected by a rare but often deadly brain-eating amoeba.
Franklin Graham has cancelled a summit on persecution to be held in Moscow over a new Russian law that is choking out Christian freedom.
A number of Chinese Christians and the lawyers that represent them are being detained by the country's national government, with little or no word on their status.
Pope Francis has lamented that children are being taught at school that gender can be a choice, adding that his predecessor, Benedict XVI has labeled current times "the epoch of sin against God the Creator."
A U.S. police officer working for the DC Metro Transit has been arrested and charged for attempting to help the Islamic State.
North Korea launches two missiles at Japan, one landing in Japanese waters.
President Barack Obama's nuclear deal with Iran could be an important issue this election year. Supporters of the deal say it will prevent Iran from getting a nuclear bomb but critics still warn that it's a bad deal.